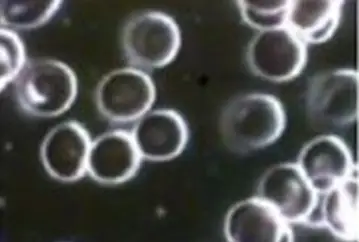

AUTRES TESTS BIOLOGIQUES
Test sur le sang fait par le laboratoire Allemand IGEF
International Society For Electrosmog-Research IGEF LTF
Test sur le sang exposé aux ondes avec un téléphone
Le microscope électronique peut montrer comment nos cellules (cellules sanguines) réagissent en présence d’ondes électromagnétiques avec et sans Multi-Déphaseur.
- On utilise un échantillon de sang sous le microscope sans être exposé aux ondes électromagnétiques pour voir les cellules sanguines normales pendant 5 minutes.
- En répétant la même expérience avec un échantillon de sang exposé aux ondes électromagnétiques d’un téléphone cellulaire pendant 5 minutes, on peut observer que les cellules sanguines s’agglomèrent et que la membrane externe devient floue.
- Même expérience avec un téléphone à l’aide d’un patch pour 5 minutes, montrant que les cellules restent presque normales

On constate une réelle différence avec et sans le Multi-Déphaseur.
